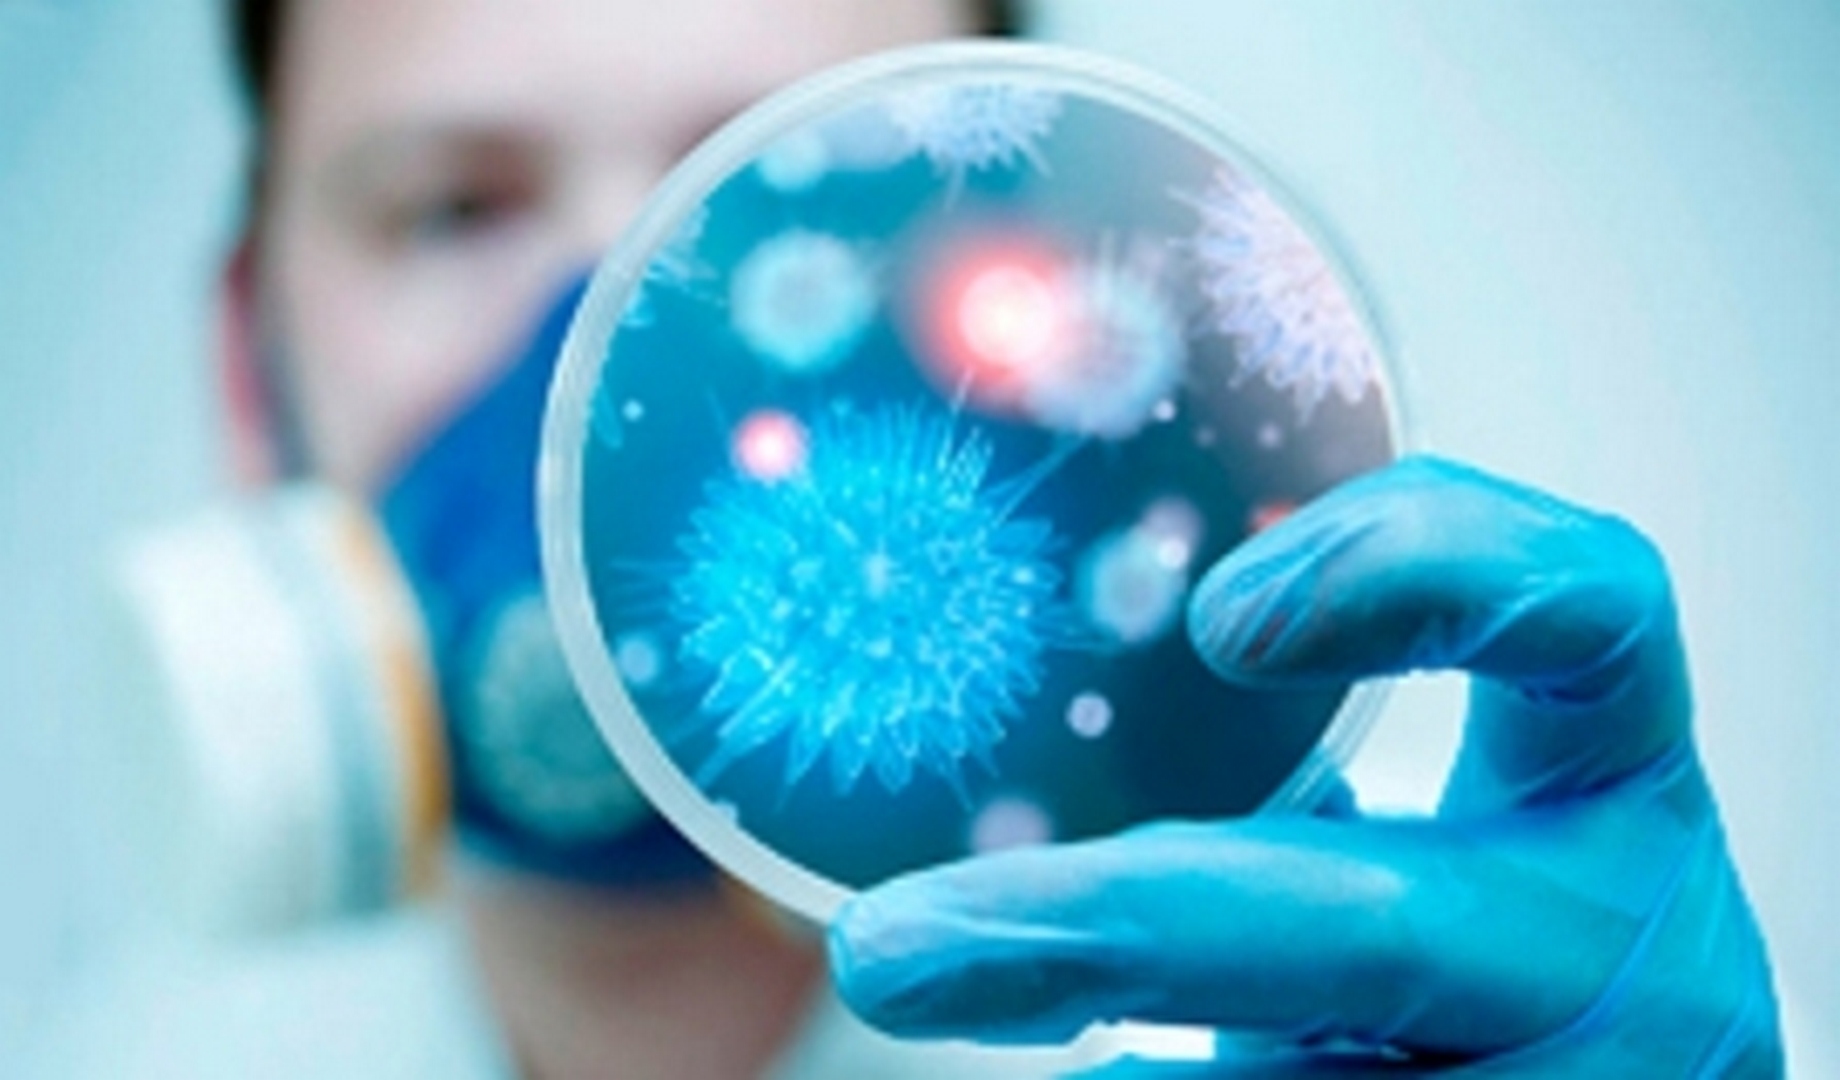

Todos los Servicios Médicos
En esta área a través del estudio de muestras obtenidas de órganos y tejidos se pueden establecer distintos grados de dolencias y/o patologías. El estudio anátomo patológico permite discernir tejidos benignos y malignos, determinar estirpes celulares o tipo tumorales y comparar órganos sanos y enfermos. Los diferentes estudios se efectúan sobre una variedad de muestras biológicas que incluyen: orina, líquido ascítico, apéndice, vesícula, biopsias de piel, cuello uterino, punciones renales, biopsias endoscópicas, punciones, etc. Las distintas aplicaciones de los resultados obtenidos pueden utilizarse en el área asistencial y en investigación y docencia, pero sin lugar a dudas lo más importante reside en la información que se le suministra al profesional médico a fin de que éste pueda establecer un diagnóstico certero y tomar una decisión terapéutica en beneficio del paciente. .

El Instituto Cardivascular del Oeste SRL desarrolla una intensa actividad con total integración a otras especialidades del Hospital. Es así que el trabajo multidisciplinario y colaborativo con cardiólogos y los otros servicios resulta cotidiano. Este servicio está integrado por un equipo de profesionales, cardiólogos, enfermeros, técnicos, auxiliares y administrativos, dedicados a las actividades asistenciales, atención integral de los pacientes con patologías cardiovascular. Se atienden pacientes con los más diversos problemas cardiovasculares como enfermedades de las arterias coronarias, de la aorta, de las válvulas cardiacas, arritmias, insuficiencia cardiaca, hipertensión arterial, alteraciones del colesterol y los lípidos, enfermedades de las arterias periféricas, etc. Cuando el caso lo requiere el paciente es derivado para la atención por un especialista en algunas de estas subespecialidades. El seguimiento alejado de los pacientes incluye no sólo acciones destinadas a modificar conductas y la0 utilización de medidas terapéuticas, sino también la rehabilitación cardiovascular. Cuenta con equipos multidisciplinarios de trabajo con amplia experiencia en cada una de las subespecialidades de la Cardiología y la tecnología más avanzada en métodos diagnósticos.

Nuestra Institución cuenta con 4 Quirófanos son un área dentro del Hospital donde se opera, o se interviene quirúrgicamente, a los pacientes. Funciona las 24 horas para cirugías de emergencia y 12 horas para cirugías programada .Se efectúan cirugías en todos los niveles de complejidad. Algunos de los tipos de cirugías que se realizan son de Cabeza y Cuello, Colorrectal, Esófago-Estómago y Bariátrica, Cirugía Hepática, Vías Biliares y Páncreas, Cirugía Oncológica, Pared Abdominal y Trasplante de Órganos. Además, se realizan procedimientos endoscópicos y percutáneos para diagnóstico y tratamiento de diferentes patologías. Cada miembro del servicio desarrolla su área de interés y se interrelaciona con los demás sectores para lograr un enfoque multidisciplinario de los pacientes y una evaluación de la calidad de los resultados (patient-centered care). El Área Quirúrgica debe manejar el flujo de actividad, la información a los familiares del paciente y la coordinación entre profesionales durante el proceso quirúrgico. Esto permite que todas las personas involucradas trabajen mejor y, al mismo tiempo, proporciona datos que permiten mejorar. El Hospital Privado busca espacio de servicios medidos por procesos controlados, que proporcione el mayor índice de seguridad, confort y efectividad para facilitar las actividades del personal, que reduzca los riesgos innecesarios y que ofrezca al paciente atención eficiente y de alta calidad. Un servicio de excelencia en alta complejidad, bajo un modelo de gestión orientado a resultados, eficiente e innovador, con profesionales comprometidos con su formación continua, que trabajen en equipo, y con tecnología de punta.

El Servicio de Clínica Médica está compuesto por un equipo de profesionales que Interno y brinda cuidado integral a los pacientes con patologías clínicas y quirúrgicas, tanto para aquellos que están en atención ambulatoria como internados. El Médico Clínico es un especialista en adultos que enfoca al paciente con una concepción integral del ser humano, capacitado para prevenir, diagnosticar, tratar y rehabilitar la patología prevalente, así como para guiar al paciente por todos los niveles de atención y realizar promoción de la salud; cumple un rol fundamental en la medicina actual. El desafío y compromiso de nuestro servicio es mejorar la calidad de atención, unificar criterios y optimizar recursos, el Servicio de Clínica Médica se desarrolla en un marco de trabajo en equipo e interdisciplinario, bajo una continua y permanente puesta al día de la ciencia médica.
Como parte de los Diagnósticos de Imagen tenemos Ecografías, que son una herramienta de vital importancia en el diagnóstico de múltiples patologías. La imagen por ultrasonido es inmediatamente visible en una pantalla de visualización para video que se asemeja a un televisor o a un monitor de computadora. La imagen se crea en base a la amplitud (potencia), frecuencia y tiempo que le lleva a la señal sonora retornar desde el área del paciente que está siendo examinada hasta el transductor y el tipo de estructura del cuerpo a través de la cual viaja el sonido. La ecografía se utiliza cada vez con más frecuencia para detectar lesiones en huesos o músculos y representa una herramienta de gran utilidad para orientar con precisión las terapias de recuperación.

La Unidad de Hemodiálisis constituye el área del Servicio de Nefrología donde se aplica la terapéutica de reemplazo de la función renal. El tratamiento sustitutivo de la función renal se aplica en aquellos enfermos que por enfermedades muy diversas han perdido más del 90% de su función renal. El procedimiento, comienza según la necesidad del paciente; comenzando con diálisis diaria y adecuándose la misma a la evolución del mismo; es muy bien tolerado. Otra de las ventajas es el monitoreo continuo del paciente y la calidad de diálisis basada en el equipamiento y características de los materiales descartables utilizados; conjunto a la seguridad que ofrece la infraestructura del Sanatorio, lo que permite atender la emergencia rápidamente. Esto le otorga a nuestros pacientes tranquilidad y seguridad.

La hemodinamia se encarga de estudiar el movimiento de la sangre a través del sistema vascular. Es definida como: “Rama de la cardiología que se especializa en el estudio del movimiento o dinámica de la sangre dentro de los vasos sanguíneos de las arterias y venas del organismo.” Esta subespecialidad de la cardiología, se basa en el diagnóstico y tratamiento de diferentes afecciones cardiovasculares, utilizando técnicas guiadas por los rayos X; suelen ser realizadas en salas de radiología vascular o en salas de hemodinamia. El Instituto Cardivascular del Oeste SRL posee una sala de hemodinamia es el lugar que cuenta con un equipamiento de alta tecnología, contiene el equipo de fluoroscopía o rayos X, para obtener las imágenes dinámicas obtenidas, procesarlas y digitalizarlas mediante un sistema de cómputo, con esto se consiguen imágenes claras y nítidas que, permiten diagnosticar y tratar las enfermedades cardiovasculares. El estudio que realiza la hemodinamia permite que encargarse del interior de las estructuras sanguíneas como: arterias, venas, vénulas, arteriolas y capilares. Por lo que se encarga del estudio y tratamiento de enfermedades como el infarto agudo al miocardio, la angina de pecho, enfermedades valvulares cardíacas, etc.

El Servicio de Hemoterapia posee una planta física ubicada en el tercer piso del Hospital, con personal técnico entrenado en las modernas técnicas de la especialidad y con equipamiento e insumos acorde a ellas. Busca alcanzar los máximos estándares de satisfacción para el cuidado de los pacientes a fin de lograr la calidad total de los productos y servicios. Su proceso de calidad se sustenta en el compromiso de la jefatura y de todos los miembros del servicio para mejorar en forma constante, reducir los costos y mantener una relación de confianza y compromiso con los pacientes. Prove servicios y productos derivados de la sangre acorde con los requerimientos de calidad y las regulaciones vigentes que garantizan su uso eficiente. Satisface las demandas de hemocomponentes (Glóbulos rojos, plaquetas, plasma y crioprecipitados) en forma segura, efectiva y confiable de manera eficaz y eficiente.

La medicina de alta complejidad requiere de múltiples medidas de prevención de las infecciones y de una vasta experiencia en la resolución de problemas infectológicos clínicos. Por ello, el Hospital Privado cuenta con un servicio dedicado a la asistencia, prevención y control de las infecciones. Se ocupa de la prevención y tratamiento de todas las infecciones que puede adquirir el ser humano (bacterianas, virales, micóticas y parasitarias), no sólo las que ocurren en gente previamente sana, sino también las que se desarrollan en pacientes con defensas disminuídas ante las infecciones tal como ocurre en los pacientes con cáncer, trasplantes de órganos sólidos, trasplantes de médula ósea (células progenitoras hematopoyéticas), infección por el VIH, etc. Desarrollamos una intensa actividad epidemiológica a través de programas específicos cuyos objetivos son evitar o minimizar las infecciones adquiridas en el hospital, el impacto clínico de las bacterias multiresistentes, así como optimizar el uso de los antimicrobianos. El Servicio de Infectología trabaja en equipo con los profesionales de todas las especialidades médicas, con un fuerte compromiso con la calidad de atención y la seguridad del paciente.
La kinesiología es una terapia natural que considera que mente y cuerpo están correlacionados, por lo que el hecho de cuidar uno de los dos aspectos, beneficiará también al otro. cumple un rol fundamental para obtener la recuperación del paciente. Esta disciplina evalúa el tono muscular y los movimientos de la persona (o los problemas que tiene para realizar un movimiento concreto), con el objetivo de identificar en qué zona del cuerpo se encuentra el problema que produce un desequilibrio al paciente, influyendo negativamente sobre su bienestar físico o emocional. Para ello se utiliza un test muscular que valora la calidad de respuesta de los distintos músculos. Como los músculos están relacionados con distintos órganos y funciones del cuerpo humano, y su respuesta no es adecuada si el sistema que lo alimenta (nervioso, sanguíneo, linfático) está bloqueado o sufre estrés. Así, a través de este examen los expertos detectan las áreas disfuncionales y las consecuencias que tiene esto sobre la salud del paciente. Una vez determinado el trastorno, el kinesiólogo emplea diversos procedimientos terapéuticos para solucionarlo, desbloqueando las zonas problemáticas, reduciendo el estrés, favoreciendo la circulación de la sangre y la oxigenación de las áreas comprimidas, etcétera. Con frecuencia el especialista también se sirve de tratamientos como la aplicación de frío o calor en la zona tratada, sesiones de acupuntura combinada, ultrasonidos, o electroestimulación, para aumentar los beneficios de la terapia. La kinesiología también se utiliza para desarrollar estilos de vida saludable y activa y prevenir la aparición de problemas de movilidad o dolencias asociadas a las malas posturas o al sedentarismo. El Servicio cuenta con profesionales especializados que atienden al paciente con un enfoque global e interdisciplinario
“Somos un equipo de trabajo orientados a la excelencia en la recuperación de nuestros pacientes, brindando a través de la experiencia una cálida atención”
En Laboratorio Hospital Privado SRL, consideramos que la salud es un pilar fundamental en la vida de una persona. Nuestro trabajo se centra en la responsabilidad de la toma y tratamiento de muestras biológicas, como en la celeridad del procesamiento de estas con el apoyo de un equipo humano competente y en constante capacitación. Brindar un servicio de diagnóstico clínico de mediana y alta complejidad, eficaz y eficiente, que sirva de herramienta a los profesionales médicos para realizar los diagnósticos pertinentes. Ser reconocidos como una empresa con una constante vocación de actualización, aplicando las nuevas técnicas y metodologías a los procesos internos en pos del mantenimiento y logro de los estándares de calidad que un paciente ambulatorio e internado puedan requerir. Responsabilidad en la labor profesional, tratándose de un ámbito en el que se encuentra en juego la salud de nuestros pacientes. Disponibilidad las 24 hs, todos los días del año, para garantizar una atención eficiente a nuestros pacientes, tanto ambulatorios como internados. Respeto por las estrictas normas de calidad aplicables a los servicios de bioquímica clínica. Desarrollo de un equipo humano altamente capacitado para llevar adelante los procesos internos de una manera eficiente. Destacamos la importancia de que los pacientes nos contacten a fin de informarles sobre las correctas metodologías de toma de muestras, para contribuir a la idoneidad de los resultados de las pruebas.

El Diagnóstico por Imagen es uno de los soportes de la actividad médica. La clave para realizar un diagnóstico preciso es disponer de la tecnología más avanzada con los profesionales mejor preparados. Nuestro objetivo es contribuir a la toma de decisiones médicas en el diagnóstico, pronóstico y tratamiento de las enfermedades, mediante la utilización adecuada de los procedimientos biofísicos que dan imágenes y del empleo de medios de contraste, trabajando de manera ordenada y uniforme de acuerdo a la estructura organizativa oficial, para que se brinde una atención eficaz, eficiente y con calidez.

Desde su creación fue concebida como una Unidad de Terapia de alta complejidad destinada a admitir pacientes adultos críticamente enfermos. De moderno diseño y excelente funcionalidad es un sanatorio polivalente, que brinda la posibilidad de un diagnóstico y tratamiento para todos y cada uno de los pacientes que diariamente concurren al mismo procurando recuperar su salud. La Terapia cuenta con 23 unidades de las cuales 2 son de aislamiento respiratorio con sistema de aire con presión positiva y presión negativa según sea el requerimiento. Esta provista de tecnología de última generación como monitores multiparamétricos, respiradores y camas. Se cuenta también con 7 unidades exclusivas para diálisis. El Hospital Ofrece a este Servicio para una atención de alta calidad centrada en los pacientes. Proporcionar atención integral de forma multidisciplinar, eficiente, segura y respetuosa con la dignidad del paciente para lograr su mejor recuperación y su máxima autonomía. Promover la implicación, satisfacción y asunción de responsabilidades de todos los trabajadores, propiciando un entorno laboral basado en la aplicación de estrategias terapéuticas de máxima calidad y la gestión del conocimiento. Compromiso con la innovación, la calidad y la excelencia. Promocionar la investigación en nuestro ámbito. Colaborar con la de otras Unidades.

El Servicio de Tomografía es la unidad orgánica encargada de proporcionar ayuda diagnóstica a través del procesamiento a e interpretación de las imágenes obtenidas de los exámenes por tomografía computarizada, efectuados para el diagnóstico y tratamiento, médico o quirúrgico de las patologías de los pacientes. Equipamiento de última generación, único en san juan que soporta pacientes de hasta 205 kg de peso. Turnos en menos de 24 horas, informes máximo 72 horas. Los profesionales y técnicos altamente especializados, trabajan en forma coordinada, ofreciendo un servicio de calidad, atención personalizada y empleando los últimos avances en prevención y En oncología, los estudios de imágenes son fundamentales para el diagnóstico, estudio de la extensión, valoración de la respuesta al tratamiento y el seguimiento de los pacientes.


